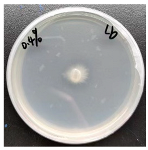
Forests 16 00413 i002
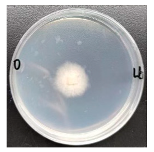
Forests 16 00413 i004
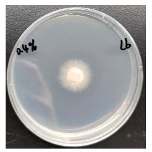
Forests 16 00413 i005
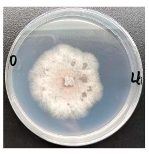
Forests 16 00413 i010
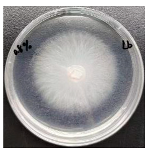
Forests 16 00413 i012

Abstract
Soil salinization is a growing global concern in many ecosystems. Although ectomycorrhizal fungi have been shown to alleviate the effects of salinity in some tree species, uncertainties persist concerning their effectiveness when plants are exposed to different salinity levels that are commonly present in salt-affected soils. Quercus dentata seedlings either non-inoculated (mycorrhizal control) or inoculated with the ectomycorrhizal fungus Laccaria bicolor were then treated with three NaCl concentrations (0, 0.4%, and 0.8%). The physiological, stoichiometric, and growth characteristics of the plants were examined. NaCl significantly affected seedling growth and physiology. However, the impact of L. bicolor on Q. dentata seedlings could shift in response to varying salt concentrations. Under moderate salinity, inoculation of L. bicolor increased root biomass by 4.55% and leaf chlorophyll concentrations by 46.8%, and decreased leaf Na+ concentrations and the Na+/K+ ratios. Under high salinity, L. bicolor decreased leaf water content and fluorescence parameters, and increased leaf Na+ concentrations. The effect of ectomycorrhizal fungus L. bicolor on Q. dentata seedlings was dependent on NaCl concentration, and our results indicate that the use of L. bicolor in afforestation efforts with Q. dentata would only be effective under relatively low soil salinity levels.
1. Introduction
Increasing soil salinization is one of the major and widespread soil factors that threatens plant survival and affects their growth and yield in many ecosystems [1,2]. Combined with progressing global climate changes and human activity, major disturbances of the ecosystems could be expected to cause a catastrophic collapse of the ecosystem states and services [3]. To achieve sustainability of agricultural production and stability of ecosystems, it is essential to prevent further salinization of soils and to develop the knowledge required to manage salt-affected sites to restore their productivity [4,5]. It is generally recognized that phytoremediation and revegetation of salinized land are appropriate but challenging tasks that can mitigate soil salinization [6,7]. For the revegetation processes, species selection and remediation methods are especially critical and may be combined with an enhancement of plant salt tolerance by beneficial microorganisms [8,9].
Plant species commonly used in saline phytoremediation are mainly halophytes [10,11,12], which have been employed to restore landscapes damaged by a variety of contaminants and disturbances [13,14]. However, other salt-tolerant plant species have also been considered for their suitability of restoration of moderately saline areas. Quercus is considered to be a tree genus with a successful evolutionary history of adaptation to changing and complex environments [15,16]. Studies have shown that some species of Quercus, including Quercus robur [17], Q. virginiana [18], and Q. ilex [19], exhibit tolerance of moderate salt levels. Therefore, the oak should be considered a potential tree species for the restoration of salt-affected areas.
In addition to selecting halophytes with superior salt tolerance [7,10], appropriate management techniques corresponding to soil regeneration are also required to improve ecosystem stability [20]. Phytoremediation with mycorrhizal fungi that can live in symbiosis with their host plants is one of the effective and sustainable methods for ecosystem stability. Mycorrhizal fungi have long been known to contribute to the stress tolerance of plants, including salinity in various plants [21,22,23,24] including oak species [25,26]. Studies have shown that inoculation with ectomycorrhizal fungi (EMF) can alleviate the toxic effects of salinity in Q. mongolica seedlings by promoting the uptake of K+ and Ca2+, which helps regulate ionic balance by increasing K+/Na+ and Ca2+/Na+ ratios [27]. Seedling height increased following inoculation, but the magnitude of the effect of different species of EMF varied [27]. Another study has also shown that inoculation with EMF improved salt tolerance in Q. mongolica seedlings by increasing in plants the contents of soluble sugars, soluble proteins, and chlorophyll, in addition to enhancing leaf stomatal conductance (gs) and intercellular CO2 concentrations (Ci), suggesting that different species of EMF may improve salt tolerance in the Quercus species via different mechanisms [28].
Within the range of salt stresses tolerated by the fungi, the host plants could be able to survive better. And the stabilization of the cooperation in mutualism might be limited by the severity of environmental stress. Fungi themselves vary in salt tolerance [29]. For example, there has been research published for different ectomycorrhizal fungi cultivated on plates [30]. Then, if salt stress in the environment is exacerbated, the survival of the fungus is bound to suffer. The contested point we need to focus on is if mycorrhizas will offer any protection to plants when they are exposed to moderate and high salt concentrations. Also, maintaining mycorrhizas is costly to the plant since the fungi drain the plant of its carbon resources. The question is, then, if the plants are severely stressed with salt, will the fungus still be helpful or will it become a burden for the plant weakened by the salt.
In the present study, we examined the effects of the ectomycorrhizal fungus Laccaria bicolor on the responses of the Daimyo oak (Quercus dentata) to relatively moderate (0.4% soil DW) and high (0.8% soil DW) NaCl concentrations. Q. dentata is a common temperate deciduous tree of medium size. Its fruit is a nut, usually encased in a cup-shaped shell hopper. The scales of the cupule are short, about 0.5–1.0 cm in length. Q. dentata has been reported to have high genetic differentiation and diversity [31], as well as superior salt tolerance even at the seedling stage [32]. The trees of this species are broadly distributed across the temperate zone of the northern hemisphere [16], and form symbiotic relationships with a wide range of ectomycorrhizal fungi [25]. Q. dentata has been widely used for vegetation restoration in fragile environments, especially in temperate regions [33]. Since ectomycorrhizal fungi vary in their effectiveness in enhancing salt tolerance to trees, the choice of an appropriate fungal species for mycorrhization of Q. dentata could help with improving the restoration efforts of areas affected by salinity. As the first sequenced ectomycorrhizal fungus [34], L. bicolor forms ectomycorrhizal associations with a wide range of host tree species and has been successfully used to improve salinity tolerance in multiple host plants [29,35,36]. A series of effector-type small, secreted proteins (SSPs) are induced to initiate phenotypical or physiological changes in ectomycorrhizal fungi or host plants during mutualistic symbiosis, by which, L. bicolor can strive for an increase in the infestation success [37]. L. bicolor, therefore, can form symbioses with multiple host plants including oaks [38]. However, most studies have examined the effects of mycorrhization on plant responses to relatively low salinity levels, and it is presently little known how effective the ectomycorrhizal fungi are in enhancing salt tolerance in plants facing the salinity levels in the soils that are classified as saline. We, therefore, carried out experiments with Q. dentata seedlings that were either non-inoculated or inoculated with the ectomycorrhizal fungus L. bicolor and exposed the seedlings to relatively moderate and high soil NaCl levels. We hypothesized that an inoculation of Q. dentata seedlings with L. bicolor will improve the salt tolerance of seedlings under both relatively moderate and high soil salinity conditions, but the effectiveness of the mycorrhization will be more pronounced under the lower level of soil salinity.
2. Materials and Methods
2.1. Seed Collection and Germination
Q. dentata acorns were collected from Zhongshan Park in Tsingtao, Shandong province, China and stored at 4 °C until Spring. Large, healthy acorns were selected and soaked in 5% H2O2 for 5 min, washed with water, and germinated in sand in a greenhouse (70% light transmittance, 25.1 °C average temperature, 80.4% average relative humidity during the experimental period). The growth substrate was composed of equal volumes of river sand and organic cultivation soil; after that, thoroughly mixed and homogenized growth substrate had been sterilized twice using high-pressure steam (121 °C, 20 min). The pH of the growth substrate is in the range of 6.5 to 7.5, and the organic matter content is ≥30%. After germination, the seedlings with a radicle of approximately the same length (2–3 cm) were selected and transferred into the pots (24 × 26 cm (diameter × height) filled with 5 kg soil) and watered daily to sustain vigorous growth.
2.2. Fungal Culture and Inoculation
The fungal strain L. bicolor UAMH8232 provided by the University of Alberta, Microfungus Collection and Herbarium, Edmonton, Canada, was cultured with modified Melin–Norkrans medium (MMN medium) [29]. After 2 weeks of cultivation in a shaking incubator (25 °C, 120 rpm), the filtered and homogenized mycelia were diluted with distilled water to 0.5 mg dry mycelia/mL [35] to make an inoculum.
One week after germination, the potted plants were divided into two equal groups. The mycorrhizal group was inoculated with L. bicolor by adding 10 mL of mycelial suspension to the soil (L.b). The soil of the second group was injected with 10 mL distilled water to serve as mycorrhizal control (CK). For the inoculation, four holes were made in the soil near the plants and the inoculum (2.5 mL) was added to each hole. The inoculation treatments were repeated every other week for a total of four times.
2.3. NaCl Treatments
NaCl treatments started two months after the root mycorrhizal inoculation. According to the results obtained from the previous study, Q. dentata seedlings were able to maintain overall growth and demonstrated a certain salt stress tolerance in 1% NaCl concentration, but above 1% concentration, plant growth would be significantly limited and could not survive normally [32]. Thus, the NaCl concentration of the experimental design is not suitable for exceeding its own salt stress tolerance ability. However, the seedlings in the previous study [32] grew to a certain stage before salt addition, whereas our NaCl treatment was for relatively early seedlings, so the salt concentration should be relatively reduced. Referring to the classification criteria of saline soils in China, soil salinity over 0.6% is classified as saline soil [39]. Therefore, in addition to the NaCl control (0% NaCl), we subjected the seedlings to two NaCl soil concentrations below (0.4% NaCl, moderate salinity treatment) and above (0.8% NaCl, high salinity treatment) this level. To avoid seedling shock response, the salt solution was added gradually to the soil. Overwatering and spilling were avoided during watering over the one month of the treatment duration to ensure that the NaCl did not leach from the soil. There were ten replicated seedlings in each treatment group (one seedling per pot), for a total of sixty seedlings (two inoculation treatments × three salinity levels × ten replicates) in the experiment.
2.4. Mycorrhizal Colonization Rate Determination
After one month of NaCl treatments, three seedlings were randomly selected from each treatment group. The first-order fine roots were carefully excised, washed with slow running water, and cut into ~1 cm long root segments. A total of 20 root segments were randomly selected from each seedling to examine for the presence of fungal hyphae and mycorrhizal structures. The roots were stained [40] and examined under the light microscope. The proportion of mycorrhizal root segments in the total number of observed roots was considered as the mycorrhizal colonization rate.
2.5. Plant Measurements
At the end of the NaCl treatments, plant heights (H) and base stem diameters (BD) were measured. Plant height was measured between the base of the plant and the shoot tip, and base stem diameter was measured with a Vernier caliper 1 cm above the soil surface.
Before harvest, mature and fully expanded functional leaves were selected for instantaneous measurements of gas exchange parameters using a portable gas exchange measurement system (Li-6800, Li-Cor, Lincoln, NE, USA). Measurements were taken between 9:00 and 12:00 h on a sunny day. Net photosynthetic rate (A), transpiration rate (E), and stomatal conductance (gs) were measured, and instantaneous water use efficiency (iWUE) was calculated as the ratio of A to E. Leaf chamber parameters were maintained as follows: leaf temperature, 28 °C; relative air humidity, 70%; light intensity, 1000 μmol·m−2·s−1; and CO2 concentration, 400 μmol·mol−1.
Chlorophyll fluorescence parameters and P700 were measured simultaneously using a portable chlorophyll fluorometer (Dual-PAM-100, Walz, Effeltrich, Germany) set to dual-channel mode. After allowing leaves to adapt to the dark for 30 min, original fluorescence (Fo) was measured, then a saturating pulse (20,000 μmol∙m−2·s−1) was performed to obtain the maximum fluorescence (Fm) and the maximum absorption change (Pm) in the dark-adapted state. After that, actinic light (400 μmol·m−2·s−1) was turned on to drive photosynthesis for 40 s, following which, a saturation pulse was performed to record the maximum fluorescence intensity of PSII (Fm’) and the maximum absorption change of PSI (Pm’). The steady-state fluorescence intensity (Ft) of PSII and steady-state absorption changes of PSI were recorded under continuous background light. Next, maximum quantum yield of PS II (Fv/Fm), photochemical quenching (qP), electron transport rate (ETR), and actual quantum yield (Y) of photosystem I and II were calculated according to the following formulae [41,42]:
where Y(NPQ) and Y(NO) correspond to the quantum yield of regulatory and non-regulatory energy dissipation, they can be obtained by the following formulae:
Fo′ = 1/(1/Fo − 1/FM + 1/FM′)
Fv/FM = (FM − Fo)/FM
qp = (FM′ − Ft)/(FM′ − Fo′)
Y(II) = 1 − Y(NPQ) − Y(NO) = (FM′ − F)/FM′
Y(I) = 1 − Y(ND) − Y(NA)
ETR(I) = 0.5 × Y(I) × 0.84 × PAR
ETR(II) = 0.5 × Y(II) × 0.84 × PAR
Y(NPQ) = F/FM′ − F/FM
Y(NO) = F/FM
Y(ND) corresponds to the fraction of P700 that is already oxidized by actinic light; Y(NA) corresponds to the fraction of P700 that are closed owing to acceptor side limitation, they can be obtained by the following formulae:
Y(ND) = P700OX/PM
Y(NA) = PM/PM′
An amount of 0.5 is the fraction of absorbed light reaching PSI or PSII; and PAR is photosynthetically active radiation, we take 0.84 of the PAR as the absorbed irradiance.
The leaf blades were collected as above for the chlorophyll concentration measurements. The leaf samples were weighed to determine fresh weights and soaked in 10 mL of 95% ethanol in the dark until the chlorophyll was fully leached out. The absorbance value of the extract was then determined by an ultraviolet-visible spectrophotometer (UV-9000s, Shanghai Metash Instruments Co., Ltd., Shanghai, China) at wavelengths of 649 and 665 nm, with 95% ethanol used as a blank control. The chlorophyll content was calculated using the following formulae [43]:
where D649 and D665 correspond to the absorbance value of the extract measured at 649 and 665 nm wavelengths, respectively.
Chlorophyll a concentration (Chl a) = 13.95 × D665 − 6.88 × D649
Chlorophyll b concentration (Chl b) = 24.96 × D649 − 7.32 × D665
Chlorophyll content = (Chl × Vleach liquor)/fresh weight
Total chlorophyll content (Chl t) = Chl a content + Chl b content
Harvested plant material was sorted into leaves, stems, and roots. Leaf fresh weight was recorded and the leaf area of 10 mature and fully unfolded leaves was measured using a scanner (LiDE120, Canon, Tokyo, Japan). Leaf dry weight was measured after drying and used to calculate the specific leaf area (SLA; leaf area/leaf dry weight) and the leaf water content (LWC; (leaf fresh weight − leaf dry weight)/leaf dry weight). We present these two indicators together, rather than separately, in the growth indicators section.
All plant fractions were heat treated at 105 °C for 30 min and oven-dried at 65 °C for 48 h, after which dry weight was collected for each portion. Seedling biomass allocation was assessed as the proportion of each part to total biomass, and included root mass ratio (RMR), stem mass ratio (SMR), and leaf mass ratio (LMR). The root–shoot ratio (R/S) was calculated as the ratio of below and above ground plant dry weight.
Next, all dried leaf, stem, and root tissues were powdered and packaged. An amount of 0.2 g from each fraction was digested by mixing with 30 mL HClO4 and HNO3 solution (v/v = 1:5) and heated to 70 °C for 10 min, followed by 40 min at 153 °C and 70 min at 190 °C. After smoke in the digestion tubes had dispersed and the liquid had cooled, the transparent liquid was transferred to a 100 mL volumetric flask and diluted to volume with deionized water. CsCl solution was added to determine the concentration of sodium and potassium ions, and LaCl3 solution was added to determine concentrations of calcium and magnesium ions. Ion concentrations were measured using an atomic absorption spectrophotometer (AA-7000, Shimadzu, Kyoto, Japan) and calculated according to corresponding dilution ratios.
Nitrogen content was determined for each fraction using the Kjeldahl method. An amount of 0.2 g of each fraction was mixed with a catalyst (CuSO4, 0.2 g; K2SO4, 3 g) and 8 mL concentrated sulfuric acid, after which it was digested by heating to 200 °C for 40 min followed by 400 °C for 40 min. The liquid was transferred to a 100 mL volumetric flask and diluted with deionized water to volume. An amount of 10 mL of the liquid under the test was taken to determined total nitrogen content of each part of the plant organs by a Kjeldahl apparatus (K9860, Hanon, Jinan, China). Another 5 mL liquid under the test was transferred to a volumetric flask (50 mL) and diluted to volume in order to determine the phosphorus content using a spectrophotometer (UV-9000s, Metash, Shanghai, China) by ascorbic acid–molybdophosphate blue method.
2.6. Statistical Analysis
A normality test and a variance homogeneity test were performed on all data before testing analysis. The effects of fungal inoculation and salt treatment on plant physiological and growth indexes of Q. dentata seedlings were analyzed by two-way analysis of variance (ANOVA) using SPSS 25.0 (SPSS Inc., Chicago, IL, USA). The responses of seedlings to different treatment combinations were analyzed by one-way analysis of variance (ANOVA). Before ANOVA analysis, data were tested for normality and homogeneity of variance first, and were log- or sqrt-transformed when necessary. Multiple comparisons were performed with a chi-squared test in order to effectively test the independence of fungal infestation and salinity stresses, and the significance levels were set at α = 0.05. There were five to six biological replicates for each measurement. Plotting was performed using Origin 2019 (OriginLab Corp., Northampton, MA, USA).
3. Results
3.1. Inoculation and Mycorrhiza Formation
There were no ectomycorrhizal structures or hyphae detected in the control group (CK). The root colonization rates were similar in the NaCl control and the 0.4% NaCl treatment. However, the root colonization rate was drastically reduced by the 0.8 NaCl treatment (Table 1).
Table 1.
Root colonization of Q. dentata seedlings in control group (CK) and inoculated seedlings (L.b) subjected to treatments with different NaCl concentrations. Different letters indicate significant differences between treatments (p < 0.05, n = 3) determined by a chi-squared test.
3.2. Effects of L. bicolor Inoculation on Growth Indicators Under Salt Stress
Prior to multiple comparisons, the effects of fungal inoculation, salt treatment, and the interactions between the two were assessed using two-way ANOVA (Table A1). Multiple comparison revealed that there was no significant difference in H and BD of the fungus-inoculated and non-inoculated seedlings under different salt stress conditions (Figure 1a,b). The leaf water content of both the inoculated and the CK seedlings under salt stress was significantly lower than that of the CK without salt stress, and leaf water content decreased by more than 50% under high salt stress (Figure 1c). Compared to the CK, the leaf water content of the inoculated seedlings was significantly lower under high salt stress, but was not significantly different compared to the other salt treatments (Figure 1c). Specific leaf area (SLA) increased with increasing salinity in both the inoculated and non-inoculated seedlings. SLA was higher in the inoculated group compared to the non-inoculated group, but this difference was only significant under moderate salt stress conditions (Figure 1d).
Figure 1.
(a) hight, (b) basal diameter, (c) leaf water content and (d) specific leaf area of Q. dentata seedlings in the control (CK) and inoculation (L.b) groups subjected to different NaCl treatment concentrations. Bars represent means of six replicates (±SE). For each parameter, bars with different letters indicate significant differences among treatments (p ≤ 0.05) determined by one-way analysis of variance (ANOVA).
Generally, root, stem, leaf, and total plant biomass decreased with increasing salinity in both the inoculated and non-inoculated seedlings. The inoculated seedlings under no salt stress showed an increase in root biomass by 44.5%, whereas under moderate salt stress, the root biomass of the inoculated seedlings increased by 27.8%. There was no significant difference in the root biomass between the inoculated and uninoculated seedlings under high salt stress (Figure 2a). Inoculation did not affect the stem or leaf biomass under different salt stress treatments (Figure 2b,c). Total seedling biomass increased by 29.8% in the inoculated group under no salt stress, but the difference was not significant (Figure 2d). Increased biomass in the inoculated group under no salt stress was mainly due to differences in the root biomass.
Figure 2.
(a) root biomass, (b) stem biomass, (c) leaf biomass and (d) total biomass of Q. dentata seedlings in the control (CK) and inoculation (L.b) groups subjected to different NaCl treatment concentrations. Bars represent means of six replicates (±SE). For each parameter, bars with different letters indicate significant differences among treatments (p ≤ 0.05) determined by one-way ANOVA.
Root mass ratio (RMR) decreased in both the control and the inoculated seedlings under salt stress. Inoculation increased RMR significantly, but only under no salt stress (Figure 3a). Neither inoculation nor NaCl treatment had a significant impact on seedling stem mass ratio (SMR) (Figure 3b). In contrast to RMR, leaf mass ratio (LMR) was significantly higher under salt stress, but inoculation did not have an effect, regardless of salt stress treatment (Figure 3c). Root–shoot ratio (R/S) followed the same trend as RMR, and inoculation significantly increased the root–shoot ratio of the seedlings, but only those in the no salt stress group (Figure 3d).
Figure 3.
Biomass allocation of Q. dentata seedlings in the control (CK) and inoculation (L.b) groups subjected to different NaCl treatment concentrations: (a) root mass ratio, (b) stem mass ratio, (c) leaf mass ratio, (d) root–shoot ratio. Bars represent means of six replicates (±SE). For each parameter, bars with different letters indicate significant differences among treatments (p ≤ 0.05) determined by one-way ANOVA.
3.3. Effects of L. bicolor on Physiological Indicators Under Salt Stress
Two-way ANOVA revealed that inoculation did not significantly affect gas exchange parameters in seedlings (Table A1), while salt stress significantly affected most gas exchange parameters (Figure 4a,b,d). Our findings suggest that plant physiological activity was increasingly restricted as salinity increased. We also note that iWUE did not exhibit the same degree of change with increasing salinity as other gas exchange parameters (Figure 4c). Inoculation reduced stomatal conductance only in the no salt stress group (Figure 4d).
Figure 4.
Gas exchange parameters of Q. dentata seedlings in the control (CK) and inoculation (L.b) groups subjected to different NaCl treatment concentrations: (a) net photosynthetic rate, (b) transpiration rate, (c) instantaneous water use efficiency, (d) stomatal conductance. Bars represent means of five replicates (±SE). For each parameter, bars with different letters indicate significant differences among treatments (p ≤ 0.05) determined by one-way ANOVA.
Salt treatment significantly reduced chlorophyll a and total chlorophyll content. Both increased in the inoculated seedlings, but this increase was significant only in the moderate salt stress treatment group (Figure 5a,c). Under salt stress, chlorophyll b content of the inoculated seedlings was slightly higher than that of the non-inoculated control group, but the difference was not significant (Figure 5b). Furthermore, inoculation did not have a significant effect on the seedlings’ chlorophyll a/b under different levels of salt stress. Chlorophyll a/b decreased with increasing soil salinity in both the inoculated and control groups (Figure 5d).
Figure 5.
Leaf chlorophyll content of Q. dentata seedlings in the control (CK) and inoculation (L.b) groups subjected to different NaCl treatment concentrations: (a) chlorophyll a content, (b) chlorophyll b content, (c) total chlorophyll content, (d) chlorophyll a/b. Bars represent means of five replicates (±SE). For each parameter, bars with different letters indicate significant differences among treatments (p ≤ 0.05) determined by one-way ANOVA.
The ETR and Y varied similarly. The ETR and Y of PS II were not significantly affected by inoculation, but gradually decreased with increasing salinity (Figure 6c,d). The ETR(I) and Y(I) both declined with increasing salinity, but the decline was exacerbated by inoculation under high-salt conditions (Figure 6a,b). Whereas Fv/Fm and qP declined only under high salt stress and, an effect that was exacerbated by inoculation, there were no significant changes in no-salt and low-salt environments (Figure 6e,f).
Figure 6.
Chlorophyll fluorescence parameters of Q. dentata seedlings in the control (CK) and inoculation (L.b) groups subjected to different NaCl treatment concentrations: (a) ETR(I), (b) Y(I), (c) ETR(II), (d) Y(II), (e) Fv/Fm and (f) qP. Bars represent means of five replicates (±SE). For each parameter, bars with different letters indicate significant differences among treatments (p ≤ 0.05) determined by one-way ANOVA.
With increasing soil salinity, Na+ content of all seedling organs increased significantly. Inoculation did not significantly affect the root and stem Na+ content; compared to the CK, however, the leaf Na+ content was significantly lower under moderate salt stress and significantly higher under high salt stress conditions (Figure 7a).
Figure 7.
Metal ion content and ratio of Q. dentata seedlings in the control (CK) and inoculation (L.b) groups subjected to different NaCl treatment concentrations: (a) Na+ content, (b) K+ content, (c) Ca2+ content, (d) Mg2+ content and (e) sodium-potassium ratio. Bars represent means of five replicates (±SE). For each parameter, bars with different letters indicate significant differences among treatments (p ≤ 0.05) determined by one-way ANOVA.
Salt stress did not have a significant effect on the root K+ content; the stem K+ decreased with increasing salinity, while the leaf K+ content increased (Figure 7b). Fungal inoculation did not affect the root or stem K+ content, but increased the leaf K+ content significantly under moderate salt stress conditions (Figure 7b). The Na+/K+ ratios increased with increasing salinity in all organs, and fungal inoculation lowered the leaf Na+/K+ ratios significantly only in low-salt environments (Figure 7e). There was no significant difference in the root, stem, or leaf Ca2+ and Mg2+ content between the inoculated and control seedlings under different salt treatments. The stem Ca2+ only increased significantly in inoculated seedlings (Figure 7c,d).
Except for the root N concentration, which increased in the CK seedlings but decreased in inoculated seedlings in high salt environments, neither salt treatment nor fungal inoculation had a significant effect on the plant organ N (Figure 8a,c,e). The plant organ P content did not change significantly in response to the NaCl treatment or fungal inoculation (Figure 8b,d,f).
Figure 8.
Nutrient concentration of Q. dentata seedlings in the control (CK) and inoculation (L.b) groups subjected to different NaCl treatment concentrations: (a) root nitrogen content, (b) root phosphorus content, (c) stem nitrogen content, (d) stem phosphorus content, (e) leaf nitrogen content and (f) leaf phosphorus content. Bars represent means of five replicates (±SE). For each parameter, bars with different letters indicate significant differences among treatments (p ≤ 0.05) determined by one-way ANOVA.
4. Discussion
4.1. Response of Q. dentata Seedlings to NaCl Treatment
The NaCl treatment appeared to have a greater impact on Q. dentata seedlings than inoculation with L. bicolor (Table A1), both in terms of growth and physiological indicators. Most parameters change monotonically with increasing salinity. Results also show that one-year old Q. dentata seedlings were resistant to relatively low salt stress and that increasing concentrations of NaCl exacerbated negative effects on seedling growth (Figure 9). This is consistent with previous work reporting salt tolerance in oaks, even at the seedling stage [18,19]. Other research has found that Q. dentata is also resistant to NaCl stress within a certain range [32]. Whether they were inoculated or not, seedlings were able to survive in saline environments (0%–0.8%), exhibiting intermediate and considerable NaCl tolerance compared with salt-tolerant species planted in afforestation projects, such as Q. virginiana, Q. acutissima [18], and Robinia pseudoacacia [44]. Our findings showing that Q. dentata has a certain degree of salt tolerance is promising for saline–alkaline land restoration.
Figure 9.
Conceptual model summarizing the effects of L. bicolor inoculation on Q. dentata seedlings under saline conditions.
With increasing salinity (0.4%), the negative effects of NaCl on seedling growth caused a decrease in plant biomass (Figure 2). Seedlings altered the nutrient and biomass distribution ratios by increasing the leaf biomass ratio and by decreasing the root biomass ratio and root–shoot ratio (Figure 3) to reduce salt uptake and upward transport by the roots and to prioritize resource allocation to the leaves for photosynthesis. This pattern of biomass distribution has also been observed in Ceriops tagal [45], a mangrove halophyte. An opposite, upward trend has been reported in Picea glauca and Pinus banksiana [29], even in individuals inoculated with L. bicolor. As soil salt content increases further (0.8%), sodium ion toxicity occurs, plant water–salt balance is disrupted, leaf tissue water loss is more serious, and leaves wither or senesce [46,47,48]. As a result, osmotic stress and ionic toxicity become stronger.
Total chlorophyll content declined significantly under increasing salt stress (Figure 5c), likely attributable to two mechanisms: (1) Na+ accumulation-induced ion toxicity impairs chlorophyll–protein binding and disrupts the chloroplast ultrastructure through thylakoid membrane degradation [49]; (2) salt-activated chlorophyllase accelerates chlorophyll a catabolism via ROS-mediated pathways [50]. The observed parallel reduction in chlorophyll a and total chlorophyll (Figure 5), coupled with decreased chlorophyll a/b ratios, demonstrates greater the salt sensitivity of chlorophyll a compared to chlorophyll b in seedlings [51].
In addition, salt stress significantly impaired photosynthetic capacity, evidenced by reduced chlorophyll content, stomatal limitations, and disrupted electron transport (Figure 4 and Figure 6) [8,52]. Declines in net photosynthetic rate, stomatal conductance, and transpiration rate were directly correlated with salinity levels, suggesting heightened photosynthetic sensitivity to soil salinity. Mechanistically, osmotic stress-induced leaf water deficits reduced guard cell turgor pressure, driving stomatal closure [51,53,54]. Concurrently, salt-induced thylakoid membrane destabilization restricted intersystem electron flow between PSII and PSI [55]. Progressive decreases in the ETR and quantum yields (Y) under elevated salinity indicated impaired light energy conversion and reaction center dysfunction [56]. While PSII maintained photosynthetic conversion capacity (qP, Fv/Fm) at moderate salinity, severe salt stress caused significant photodamage and functional impairment [57]. This dual-phase response highlights threshold-dependent salt tolerance mechanisms in photosynthetic apparatus.
4.2. Positive Effects of L. bicolor on Q. dentata Seedlings Under Moderate Salinity
EMF partner with many woody plants and usually maintain reciprocal symbiosis [58]. Plants provide fungi with a portion of the carbohydrate fixed by photosynthesis and fungi help the plant absorb water and nutrients in return, improving resilience [59]. Here, inoculation worked in Q. dentata seedlings and played a beneficial role in non-hypersaline environments.
Our findings indicate a complex interaction between salinity and fungal symbiosis. We found that inoculation under salt-free conditions significantly increased the root biomass of the Q. dentata seedlings, resulting in higher total biomass for the inoculated group compared to the CK. The root–shoot ratio was also significantly higher among the inoculated seedlings, indicating that colonization by EMF promotes root growth in Q. dentata seedlings and increases the proportion of resources allocated below ground, enhancing plant uptake and storage of water and nutrients [60]. In addition, we also found that symbiosis with L. bicolor improves seedling salt tolerance under moderate salinity. Under relatively low NaCl stress, L. bicolor induced the host plants to expand their roots (Figure 2a) to alleviate the osmotic stress and to supply the leaves with adequate water (Figure 1c), representing a trade-off between its own water absorption capacity and the osmotic pressure caused by salt stress. Likewise, ion toxicity to plant leaves decreased proportionally with decreasing sodium–potassium ratios in relation to sodium ion concentrations (Figure 7a,e), which resulted from the increased water supply to the leaves. As a result, the total chlorophyll content of Q. dentata seedlings increased with increasing chlorophyll a content under relatively low salt stress (Figure 5a,c) to mitigate the degradative effects of salt stress [61]. This is consistent with previous research, and is probably due to the fact that the symbiotic fungus secretes growth regulators, such as cytokinins, thereby increasing leaf chlorophyll content [62]. Our findings suggest that symbiosis with L. bicolor has a positive effect on Q. dentata seedling growth and can promote seedling growth under moderate salt stress.
4.3. Negative Effects of L. bicolor on Q. dentata Seedlings Under High Salinity
Symbiotic relationships between mycorrhizal fungi and host plants are not unbreakable [63], and cooperation becomes uneven when resource exchange is diminished or stops in response to environmental stress [64,65]. As soil salinity gradually exceeds the normal tolerance range of plants, the relationship between symbiotic mycorrhiza and the host plant becomes more subtle [66,67]. The effects of EMF inoculation on various indicators, like tissue biomass, gas exchange parameters, chlorophyll content, chlorophyll fluorescence parameters, and sodium–potassium ratio, were weaker under high salt stress. Regardless, the mycorrhizal association did not provide any benefit to the host plants when the seedlings were unable to withstand the damage caused by salt stress (Figure 9). At the same time, we found that moderate NaCl promotes the growth of L. bicolor mycelium (Table A2), consistent with previous research demonstrating the salt tolerance of the L. bicolor [68]. As salinity increases, the ability of the fungus to generate its own growth as well as its vigor to colonize and live in symbiosis with the host plant decreases; in particular, mycorrhizal colonization rates are significantly lower under high salt conditions than they are under no-salt and medium-salt conditions (Table 1). The high salinity environment could raise the threshold of fungal competitiveness to the host plants; L. bicolor that colonize Q. dentata seedlings not only become less numerous but play a negative role in plant growth.
In relatively harsh environments, where fungus is restricted in its own growth and its protective effect on plants from NaCl is lost, the limited available resources made by the seedlings face intense competition from both the fungus and the host plant, and the fungus will rob the survival resources from the plants thereby inhibiting their growth. Thus, host plants are unable to meet the mycorrhizal demand for resources, which remain high under saline conditions, and exacerbated nutrient and water stress reduce root nitrogen (Figure 8a) and the leaf water content (Figure 1c). As the main photosynthetic organ, leaves accumulate sodium when water is lost [69] and experience worsening ion toxicity (Figure 7a). Chlorophyll fluorescence parameters, which are sensitive to ion penetration and water–salt balance, also decrease (Figure 6).
Notably, our results suggest that leaf Na+ content is a sensitive and critical indicator of fungal colonization under different salt stress conditions. That is, when plant growth is limited primarily by environmental salt stress, the physiological changes induced by a plant’s association with symbiotic mycorrhizal fungi are most obvious in the leaf Na+ content (Figure 7). Inoculation with L. bicolor reduces photosystem efficiency in highly saline soil. Moreover, the effect of salt stress on photosynthetic efficiency is most apparent in changes in the ETR and Y of photosystem I, which are more sensitive to the effects of fungal inoculation than those of photosystem II (Figure 6). Severe salinity decreases PSII stability and donor side intactness [55] which were maintained under relatively low salt stress (Figure 6e,f). Fungal inoculation further jeopardizes the stability of the photosynthetic apparatus under high salt conditions (Figure 6). These results indicate that mycorrhizal association with L. bicolor can help Q. dentata seedlings maintain photosynthesis and mitigate oxidative damage under moderate salt stress, although the symbiotic system becomes ineffective at elevated salt stress concentrations. Consequently, the inclusion of mycorrhizal symbiosis in afforestation strategies for saline–alkali soils necessitates the monitoring of key physiological and biochemical parameters, particularly chlorophyll fluorescence indices and ionic homeostasis markers, to optimize symbiotic efficacy in challenging edaphic conditions.
4.4. Implications for Afforestation Activities in Saline Areas
Many oak species are tolerant to salt stress and have potential applications in land afforestation in saline–alkali soil [19,70]. Research conducted in the Basianshan National Nature Reserve has shown that Q. dentata plays a crucial pioneering role in the early stages of forest restoration, contributing to the formation of stable dominant populations and improving community structure and diversity [33].
Moreover, the genome-wide identification and expression analysis of the ZIP gene family in Q. dentata have revealed its capability in heavy metal transport, particularly zinc, which underscores its potential in the phytoremediation of contaminated soils [71]. This genetic insight aligns with the findings that Q. dentata can effectively absorb and transport essential trace elements, thereby mitigating soil pollution and enhancing soil health [72].
Ecologically, Q. dentata contributes to the improvement of soil enzyme activities and nutrient cycling, which are essential for maintaining soil fertility and promoting plant growth under stress conditions such as drought and nitrogen enrichment [72]. The ability of this species to adapt to various environmental stresses and improve soil conditions makes it a valuable asset in ecological restoration projects.
Mycorrhizal fungi have a strong regulatory effect on root exudation and nitrogen uptake in temperate tree species [73]. Afforestation studies suggest that EMF symbiosis during silviculture can enhance carbon sequestration and improve soil properties [74,75]. Although it is possible that afforestation, combined with carefully selected EMF symbionts, can improve saline–alkali soil [76,77], the mechanisms underpinning these improvements and the potential use of EMF, including L. bicolor, are still poorly understood.
It appears that, in this study, L. bicolor was effective only under the moderate salinity level because the fungus itself could not tolerate higher salt concentrations, as shown by a reduction in root colonization under the high salt concentration (Table 1). It is proved that the survival and mycelial extension of L. bicolor cultured in vitro were not significantly affected under higher salt concentration (Table A2). It is a fact that L. bicolor is one kind of mycorrhizal fungi with strong saline–alkali tolerance [78] and even certain salinity could promote the proliferation of fungi in vitro (Table A2), while the higher salinity level might restrict the inoculation of EMF, as shown by less colonization density on the same individual (Table 1). Because of the decline in co-benefits, the probability of L. bicolor to refuse to inoculate plants increases under high salinity concentrations. Therefore, the effectiveness of the fungus in conferring salt tolerance to plants can be only up to the salt concentration that the fungus can tolerate itself. It is the salt concentration in vitro that may not only be too high for the mycorrhizal fungi combined with plants in afforestation to be survival, but determines the activeness and effectiveness in conferring salt protection to the plants. Therefore, it is necessary to consider the effect of fungal cooperative afforestation according to the requirements and adaptability of applied fungi to the soil environment. Furthermore, a deeper understanding is needed of the long-term effects of salinity on Q. dentata–L. bicolor symbionts and the underlying mechanisms.
5. Conclusions
In our study, mycorrhization with L. bicolor had either a positive or a negative impact on plant responses to NaCl depending on the soil salt. Here, this association helped plants cope with salt stress by promoting the root growth, increasing the light capture area, promoting chlorophyll accumulation, and regulating the ion balance under moderate salt stress. By contrast, EMF association under high salt stress exacerbated nutrient stress, water stress, and Na+ toxicity, leading to a decrease in plant photosynthetic activity, rate, and yield. Therefore, mycorrhizal seedlings inoculated with EMF can be considered for vegetation restoration in mildly saline soil, which supports Quercus growth. However, when the soil salinity is high beyond a certain range, it is necessary to fully consider not only the salt tolerance of Quercus themselves, but the survival of the symbiotic fungi in saline environments and the actual effect of mycorrhizal symbiosis, under which mycorrhizal means may not be applicable. Collectively, afforestation with Q. dentata seedlings combined with symbiosis with L. bicolor is a reasonable choice with broad application prospects. The symbiont of L. bicolor and Q. dentata, with its remarkable adaptability and multifunctional benefits, holds significant potential for real-world applications, particularly in afforestation projects and soil remediation initiatives. Its ability to enhance forest community stability and diversity makes it an ideal candidate for partnerships in large-scale afforestation projects. However, additional research investigating the genetic and molecular mechanisms driving enhanced salt tolerance is needed to maximize the benefits of the interaction between L. bicolor and Q. dentata.
Author Contributions
All authors contributed to the study conception and design. Material preparation, data collection, and analysis were performed by W.S., H.C., Y.S. and L.Q. The first draft of the manuscript was written by W.S. and all authors commented on previous versions of the manuscript. All authors have read and agreed to the published version of the manuscript.
Funding
This study was funded by the Natural Science Foundation of Shandong Province, China (No. ZR2020MC035, No. ZR2024MC012), Shandong Province “Double-Hundred Talent Plan” Project (No. WSG2018023), Seed funding for International Scientific Research Cooperation of Shandong University (No. SD202015), and Key Research and Development Program of Shandong Province, China (No. 2021CXGC010803).
Data Availability Statement
Data will be made available from the corresponding author on reasonable request.
Acknowledgments
We thank Chengjia Zhang and Nannan Dong of the Core Facilities for Life and Environmental Sciences, State Key laboratory of Microbial Technology of Shandong University for metal ion assay and analysis.
Conflicts of Interest
The authors declare no conflicts of interest.
Abbreviations
The following abbreviations are used in this manuscript:
| EMF | Ectomycorrhizal fungi |
| SLA | Specific leaf area |
| RMR | Root mass ratio |
| SMR | Stem mass ratio |
| LMR | Leaf mass ratio |
Appendix A
Appendix A.1
Table A1.
Two-way analysis of variance (ANOVA) on all measured indicators of Q. dentata seedlings under fungus inoculation and salt treatment.
Table A1.
Two-way analysis of variance (ANOVA) on all measured indicators of Q. dentata seedlings under fungus inoculation and salt treatment.
| Plant Traits | F Value and Its Significance | ||
|---|---|---|---|
| Fungus Inoculation | Soil Salinity | Interaction Effects | |
| Height (cm) | 0.094 | 1.798 | 0.161 |
| Basal diameter (mm) | 0.661 | 17.46 *** | 2.733 |
| Leaf water content (%) | 5.547 * | 485.198 *** | 3.277 |
| SLA (cm2 g−1) | 16.562 *** | 6.131 ** | 0.652 |
| Total biomass (g) | 8.486 *** | 115.954 *** | 6.165 *** |
| Root biomass (g) | 31.085 *** | 251.122 *** | 14.307 *** |
| Stem biomass (g) | 1.096 | 38.333 *** | 1.185 |
| Leaf biomass (g) | 0.952 | 29.783 *** | 1.934 |
| RMR | 4.305 * | 17.907 *** | 0.070 |
| SMR | 0.663 | 0.163 | 0.194 |
| LMR | 4.096 | 30.781 *** | 0.173 |
| R/S | 5.920 *** | 24.919 *** | 0.383 |
| Net photosynthetic rate (μmol m−2 s−1) | 0.568 | 40.001 *** | 1.506 |
| Transpiration rate (mmol m−2 s−1) | 0.375 | 40.475 *** | 0.573 |
| Instantaneous water use efficiency (mmol mol−1) | 0.381 | 3.000 | 1.003 |
| Stomatal conductance (mol m−2 s−1) | 1.668 | 54.428 *** | 1.571 |
| Chlorophyll a (mg g−1) | 3.391 * | 31.083 *** | 2.083 |
| Chlorophyll b (mg g−1) | 4.534 * | 3.657 * | 0.501 |
| Total chlorophyll (mg g−1) | 4.428 * | 17.895 *** | 1.508 |
| Chlorophyll a/b | 0.486 | 34.169 *** | 0.419 |
| Maximum quantum yield of photosystem II | 1.353 | 11.559 *** | 1.705 |
| Photochemical quenching | 12.054 ** | 140.885 *** | 15.256 *** |
| Relative electron transport rate of photosystem I (µmol m−2 s−1) | 1.259 | 51.444 ** | 2.002 |
| Actual quantum yield of photosystem I | 1.292 | 51.809 *** | 1.995 |
| Relative electron transport rate of photosystem II (µmol m−2 s−1) | 0.441 | 42.891 *** | 0.093 |
| Actual quantum yield of photosystem II | 0.447 | 42.682 *** | 0.093 |
| Root Na+ content | 0.393 | 23.507 *** | 0.197 |
| Stem Na+ content | 2.779 | 93.984 *** | 0.198 |
| Leaf Na+ content | 19.099 ** | 219.260 *** | 5.476 * |
| Root K+ content | 2.749 | 2.621 | 0.539 |
| Stem K+ content | 1.616 | 4.605 * | 3.282 |
| Leaf K+ content | 3.831 | 3.138 | 2.795 |
| Root Ca2+ content | 0.453 | 2.890 | 2.382 |
| Stem Ca2+ content | 2.239 | 6.655 * | 1.624 |
| Leaf Ca2+ content | 0.338 | 2.890 | 1.367 |
| Root Mg2+ content | 0.031 | 0.819 | 0.043 |
| Stem Mg2+ content | 2.165 | 1.771 | 0.277 |
| Leaf Mg2+ content | 0.748 | 1.560 | 0.374 |
| Sodium–potassium ratio | 0.061 | 43.960 *** | 1.858 |
| Root nitrogen content | 1.130 | 4.922 * | 4.541 * |
| Root phosphorus content | 2.221 | 6.621 ** | 0.025 |
| Stem nitrogen content | 0.140 | 4.511 * | 2.253 |
| Stem phosphorus content | 0.004 | 3.489 | 0.040 |
| Leaf nitrogen content | 0.571 | 2.949 | 1.756 |
| Leaf phosphorus content | 0.569 | 0.237 | 2.136 |
The abbreviations in the table represent as follows: specific leaf area (SLA), root mass ratio (RMR), stem mass ratio (SMR), leaf mass ratio (LMR), root–shoot ratio (R/S). The significance of each effect is indicated by *: * indicates p < 0.05, ** indicates p < 0.01, and *** indicates p < 0.001.
Appendix A.2
Table A2.
Growth changes of L. bicolor in solid culture under different salt stress.
Table A2.
Growth changes of L. bicolor in solid culture under different salt stress.
| Growth Time | NaCl Content in the Culture Medium | ||
|---|---|---|---|
| 0 | 0.4% | 0.8% | |
| One day | ![]() | ![]() | ![]() |
| Three days | ![]() | ![]() | ![]() |
| Five days | ![]() | ![]() | ![]() |
| Seven days | ![]() | ![]() | ![]() |
References
- Kopittke, P.M.; Menzies, N.W.; Wang, P.; McKenna, B.A.; Lombi, E. Soil and the intensification of agriculture for global food security. Environ. Int. 2019, 132, 105078. [Google Scholar] [CrossRef] [PubMed]
- Singh, A. Soil salinization management for sustainable development: A review. J. Environ. Manag. 2021, 277, 111383. [Google Scholar] [CrossRef] [PubMed]
- Negacz, K.; Malek, Z.; de Vos, A.; Vellinga, P. Saline soils worldwide: Identifying the most promising areas for saline agriculture. J. Arid Environ. 2022, 203, e104775. [Google Scholar] [CrossRef]
- Ullah, S.; Dahlawi, S.; Naeem, A.; Rengel, Z.; Naidu, R. Biochar application for the remediation of salt-affected soils: Challenges and opportunities. Sci. Total. Environ. 2017, 625, 320–335. [Google Scholar]
- Mukhopadhyay, R.; Sarkar, B.; Jat, H.S.; Sharma, P.C.; Bolan, N.S. Soil salinity under climate change: Challenges for sustainable agriculture and food security. J. Environ. Manag. 2021, 280, 111736. [Google Scholar] [CrossRef]
- Crooks, S.; Sutton-Grier, A.E.; Troxler, T.G.; Herold, N.; Bernal, B.; Schile-Beers, L.; Wirth, T. Coastal wetland management as a contribution to the US National Greenhouse Gas Inventory. Nat. Clim. Change 2018, 8, 1109–1112. [Google Scholar] [CrossRef]
- Litalien, A.; Zeeb, B. Curing the earth: A review of anthropogenic soil salinization and plant-based strategies for sustainable mitigation. Sci. Total Environ. 2020, 698, 134235. [Google Scholar] [CrossRef]
- Van Zelm, E.V.; Zhang, Y.X.; Testerink, C. Salt tolerance mechanisms of plants. Annu. Rev. Plant Biol. 2020, 71, 403–433. [Google Scholar] [CrossRef]
- Hao, S.H.; Wang, Y.R.; Yan, Y.X.; Liu, Y.H.; Wang, J.Y.; Chen, S. A review on plant responses to salt stress and their mechanisms of salt resistance. Horticulturae 2021, 7, 132. [Google Scholar] [CrossRef]
- Ruan, C.J.; de Silva, J.A.T.; Mopper, S.; Qin, P.; Lutt, S. Halophyte improvement for a salinized world. Crit. Rev. Plant Sci. 2010, 29, 329–359. [Google Scholar] [CrossRef]
- Manousaki, E.; Kalogerakis, N. Halophytes—An emerging trend in phytoremediation. Int. J. Phytoremediat 2011, 13, 959–969. [Google Scholar] [CrossRef] [PubMed]
- Stavi, I.; Thevs, N.; Priori, S. Soil salinity and sodicity in drylands: A review of causes, effects, monitoring, and restoration measures. Front. Environ. Sci. 2021, 9, 712831. [Google Scholar] [CrossRef]
- Manousaki, E.; Kalogerakis, N. Halophytes present new opportunities in phytoremediation of heavy metals and saline soils. Ind. Eng. Chem. Res. 2011, 50, 656–660. [Google Scholar] [CrossRef]
- Liang, L.C.; Liu, W.T.; Sun, Y.B.; Huo, X.H.; Li, S.; Zhou, Q.X. Phytoremediation of heavy metal contaminated saline soils using halophytes: Current progress and future perspectives. Environ. Rev. 2017, 25, 269–281. [Google Scholar] [CrossRef]
- Kremer, A.; Hipp, A.L. Oaks: An evolutionary success story. New Phytol. 2019, 226, 987–1011. [Google Scholar] [CrossRef]
- Sork, V.L.; Cokus, S.J.; Fitz-Gibbon, S.T.; Zimin, A.V.; Puiu, D.; Garcia, J.A.; Gugger, P.F.; Henriquez, C.L.; Zhen, Y.; Lohmueller, K.E.; et al. High-quality genome and methylomes illustrate features underlying evolutionary success of oaks. Nat. Commun. 2022, 13, 2047. [Google Scholar] [CrossRef]
- Alaoui-Sossé, B.; Sehmer, L.; Barnola, P.; Dizengremel, P. Effect of NaCl salinity on growth and mineral partitioning in Quercus robur L. a rhythmically growing species. Trees 1998, 12, 424–430. [Google Scholar] [CrossRef]
- Wang, S.F.; Hu, Y.X.; Sun, H.J.; Shi, X.; Pan, H.W.; Chen, Y.T. Effects of salt stress on growth and root development of two oak seedlings. Acta. Ecol. Sin. 2014, 34, 1021–1029. [Google Scholar]
- Gugliuzza, G.; Gentile, C.; Scuderi, D.; Palazzolo, E.; Farina, V. Effects of salt stress on growth of Quercus ilex L. seedlings. Open Agric. 2023, 8, 20220211. [Google Scholar] [CrossRef]
- Jesus, J.M.; Danko, A.S.; Fiúza, A.; Borges, M.T. Phytoremediation of salt-affected soils: A review of processes, applicability, and the impact of climate change. Environ. Sci. Pollut. R. 2015, 22, 6511–6525. [Google Scholar] [CrossRef]
- Muhsin, T.M.; Zwiazek, J.J. Colonization with Hebeloma crustuliniforme increases water conductance and limits shoot sodium uptake in white spruce (Picea glauca) seedlings. Plant Soil 2002, 238, 217–225. [Google Scholar] [CrossRef]
- Begum, N.; Qin, C.; Ahanger, M.A.; Raza, S.; Khan, M.I.; Ashraf, M.; Ahmed, N.; Zhang, L.X. Role of Arbuscular Mycorrhizal Fungi in Plant Growth Regulation: Implications in Abiotic Stress Tolerance. Front. Plant Sci. 2019, 10, 1068. [Google Scholar] [CrossRef] [PubMed]
- Klinsukon, C.; Lumyong, S.; Kuyper, T.W.; Boonlue, S. Colonization by arbuscular mycorrhizal fungi improves salinity tolerance of eucalyptus (Eucalyptus camaldulensis) seedlings. Sci. Rep. 2021, 11, 4362. [Google Scholar] [CrossRef] [PubMed]
- Peng, Z.C.; Zulfiqar, T.; Yang, H.C.; Wang, M.; Zhang, F.H. Effect of Arbuscular Mycorrhizal Fungi (AMF) on photosynthetic characteristics of cotton seedlings under saline-alkali stress. Sci. Rep. 2024, 14, 8633. [Google Scholar] [CrossRef]
- Arai, H.; Tamai, Y.; Yajima, T.; Obase, K.; Miyamato, T. Ectomycorrhizal fungal communities associated with Quercus dentata in a coastal broadleaf forest. Mycosphere 2017, 8, 561–567. [Google Scholar] [CrossRef]
- Guerrero-Galán, C.; Calvo-Polanco, M.; Zimmermann, S.D. Ectomycorrhizal symbiosis helps plants to challenge salt stress conditions. Mycorrhiza 2019, 29, 291–301. [Google Scholar] [CrossRef]
- Guo, W.; Hao, H.; Zhang, W.H.; Hu, Z.H.; Leng, P.S. Ectomycorrhizal fungi enhance salt tolerance of Quercus mongolica by regulating ion balance. Chin. J. Appl. Ecol. 2022, 33, 3303–3311. [Google Scholar]
- Bai, X.N.; Hao, H.; Hu, Z.H.; Leng, P.S. Ectomycorrhizal inoculation enhances the salt tolerance of Quercus mongolica seedlings. Plants 2021, 10, 1790. [Google Scholar] [CrossRef]
- Bois, G.; Bigras, F.J.; Bertrand, A.; Piché, Y.; Fung, M.Y.P.; Khasa, D.P. Ectomycorrhizal fungi affect the physiological responses of Picea glauca and Pinus banksiana seedlings exposed to an NaCl gradient. Tree Physiol. 2006, 26, 1185–1196. [Google Scholar] [CrossRef]
- Tang, M.; Sheng, M.; Chen, H.; Zhang, F.F. In vitro salinity resistance of three ectomycorrhizal fungi. Soil Biol. Biochem. 2009, 41, 948–953. [Google Scholar] [CrossRef]
- Zhou, B.F.; Shi, Y.; Chen, X.Y.; Yuan, S.; Liang, Y.Y.; Wang, B.S. Linked selection, ancient polymorphism, and ecological adaptation shape the genomic landscape of divergence in Quercus dentata. J. Syst. Evol. 2022, 60, 1344–1357. [Google Scholar] [CrossRef]
- Hao, H.; Cao, L.; Chen, W.N.; Hu, Z.H.; Leng, P.S. Effects of salt stress on the ion balance and physiological-biochemical characteristics of Quercus dentata seedlings. Acta. Ecol. Sin. 2020, 40, 6897–6904. [Google Scholar]
- Qiu, Z.L.; Zhang, M.; Wang, K.F.; Shi, F.C. Vegetation community dynamics during naturalized developmental restoration of Pinus tabulaeformis plantation in North warm temperate zone. J. Plant Ecol. 2023, 16, rtac102. [Google Scholar] [CrossRef]
- Martin, F.; Aerts, A.; Ahrén, D.; Brun, A.; Danchin, E.G.J.; Duchaussoy, F.; Gibon, J.; Kohler, A.; Lindquist, E.; Pereda, V.; et al. The genome of Laccaria bicolor provides insights into mycorrhizal symbiosis. Nature 2008, 452, 88–92. [Google Scholar] [CrossRef] [PubMed]
- Polanco, M.C.; Zwiazek, J.J.; Voicu, M.C. Responses of ectomycorrhizal American elm (Ulmus americana) seedlings to salinity and soil compaction. Plant Soil 2008, 308, 189–200. [Google Scholar] [CrossRef]
- Xu, H.; Kemppainen, M.; El Kayal, W.; Lee, S.H.; Pardo, A.G.; Cooke, J.E.K.; Zwiazek, J.J. Overexpression of Laccaria bicolor aquaporin JQ585595 alters root water transport properties in ectomycorrhizal white spruce (Picea glauca) seedlings. New Phytol. 2015, 205, 757–770. [Google Scholar] [CrossRef]
- Plett, J.M.; Kemppainen, M.; Kale, S.D.; Kohler, A.; Legué, V.; Brun, A.; Tyler, B.M.; Pardo, A.G.; Martin, F. A secreted effector protein of Laccaria bicolor is required for symbiosis development. Curr. Biol. 2011, 21, 1197–1203. [Google Scholar] [CrossRef]
- Shi, N.N.; Guo, C.; Zheng, Y.; Guo, L.D. Effects of ectomycorrhizal fungal identity and diversity on subtropical tree competition. J. Plant Ecol. 2017, 10, 47–55. [Google Scholar] [CrossRef]
- Wang, Z.Q. Saline Soils in China, 1st ed.; Science Press: Beijing, China, 1993; pp. 133–139. [Google Scholar]
- Phillips, J.M.; Hayman, D.S. Improved procedures for clearing roots and staining parasitic and vesicular-arbuscular mycorrhizal fungi for rapid assessment of infection. Trans. Br. Mycol. Soc. 1970, 55, 158–160. [Google Scholar] [CrossRef]
- Lu, C.M.; Zhang, J.H. Effects of water stress on photosystem II photochemistry and its thermostability in wheat plants. J. Exp. Bot. 1999, 50, 1199–1206. [Google Scholar] [CrossRef]
- Maxwell, K.; Johnson, G.N. Chlorophyll fluorescence—A practical guide. J. Exp. Bot. 2000, 51, 659–668. [Google Scholar] [CrossRef] [PubMed]
- Lichtenthaler, H.K.; Wellburn, A.R. Determinations of total carotenoids and chlorophylls a and b of leaf extracts in different solvents. Biochem. Soc. T. 1983, 11, 591–592. [Google Scholar] [CrossRef]
- Mao, P.L.; Zhang, Y.J.; Cao, B.H.; Guo, L.M.; Shao, H.B.; Cao, Z.Y.; Jiang, Q.K.; Wang, X. Effects of salt stress on eco-physiological characteristics in Robinia pseudoacacia based on salt-soil rhizosphere. Sci. Total Environ. 2016, 568, 118–123. [Google Scholar] [CrossRef] [PubMed]
- Patel, N.T.; Gupta, A.; Pandey, A.N. Strong positive growth responses to salinity by Ceriops tagal, a commonly occurring mangrove of the Gujarat coast of India. AoB. Plants 2010, 2010, pjq011. [Google Scholar] [CrossRef]
- Horie, T.; Hauser, F.; Schroeder, J.I. HKT transporter-mediated salinity resistance mechanisms in Arabidopsis and monocotcrop plants. Trends Plant Sci. 2009, 14, 660–668. [Google Scholar] [CrossRef]
- Hammer, E.C.; Nasr, H.; Pallon, J.; Olsson, P.A.; Wallander, H. Elemental composition of arbuscular mycorrhizal fungi at high salinity. Mycorrhiza 2011, 21, 117–129. [Google Scholar] [CrossRef]
- Heng, T.; He, X.L.; Yang, G.; Tian, L.J.; Li, F.D.; Yang, L.L.; Zhao, L.; Feng, Y.; Xu, X. Growth and nitrogen status of cotton (Gossypium hirsutum L.) under salt stress revealed using 15N-labeled fertilizer. J. Plant Ecol. 2022, 15, 1213–1226. [Google Scholar] [CrossRef]
- Pardo, J.M. Biotechnology of water and salinity stress tolerance. Curr. Opin. Biotech. 2010, 21, 185–196. [Google Scholar] [CrossRef]
- Li, J.M.; Hu, L.P.; Zhang, L.; Pan, X.B.; Hu, X.H. Exogenous spermidine is enhancing tomato tolerance to salinity–alkalinity stress by regulating chloroplast antioxidant system and chlorophyll metabolism. BMC Plant Biol. 2015, 15, 303. [Google Scholar] [CrossRef]
- Akram, M. Effects of nitrogen application on chlorophyll content, water relations, and yield of maize hybrids under saline conditions. Commun. Soil Sci. Plan. 2014, 45, 1336–1356. [Google Scholar] [CrossRef]
- Sudhir, P.; Murthy, S.D.S. Effects of salt stress on basic processes of photosynthesis. Photosynthetica 2004, 42, 481–486. [Google Scholar] [CrossRef]
- Bose, J.; Munns, R.; Shabala, S.; Gilliham, M.; Pogson, B.; Tyerman, S. Chloroplast function and ion regulation in plants growing on saline soils: Lessons from halophytes. J. Exp. Bot. 2017, 68, 3129–3143. [Google Scholar] [CrossRef]
- Tombesi, S.; Nardini, A.; Frioni, T.; Soccolini, M.; Zadra, C.; Farinelli, D.; Poni, S.; Palliotti, A. Stomatal closure is induced by hydraulic signals and maintained by ABA in drought-stressed grapevine. Sci. Rep. 2015, 5, 12449. [Google Scholar] [CrossRef] [PubMed]
- Zahra, N.; Al Hinai, M.S.; Hafeez, M.B.; Rehman, A.; Wahid, A.; Siddique, K.H.M.; Farooq, M. Regulation of photosynthesis under salt stress and associated tolerance mechanisms. Plant Physiol. Bioch. 2022, 178, 55–69. [Google Scholar] [CrossRef] [PubMed]
- Gururani, M.A.; Venkatesh, J.; Tran, L.P. Regulation of photosynthesis during abiotic stress-induced photoinhibition. Mol. Plant 2015, 8, 1304–1320. [Google Scholar] [CrossRef] [PubMed]
- Humeed, A.; Ahmed, M.Z.; Hussain, T.; Aziz, I.; Ahmad, N.; Gul, B.; Nielsen, B.L. Effects of salinity stress on chloroplast structure and function. Cells 2021, 10, 2023. [Google Scholar] [CrossRef]
- Genre, A.; Lanfranco, L.; Perotto, S.; Bonfante, P. Unique and common traits in mycorrhizal symbioses. Nat. Rev. Microbiol. 2020, 18, 649–660. [Google Scholar] [CrossRef]
- Bahadur, A.; Batool, A.; Nasir, F.; Jiang, S.J.; Qin, M.S.; Zhang, Q.; Pan, J.B.; Liu, Y.J.; Feng, H.Y. Mechanistic insights into arbuscular mycorrhizal fungi-mediated drought stress tolerance in plants. Int. J. Mol. Sci. 2019, 20, 4199. [Google Scholar] [CrossRef]
- Wang, R.Z.; Chen, L.; Bai, Y.G.; Xiao, C.W. Seasonal dynamics in resource partitioning to growth and storage in response to drought in a perennial rhizomatous grass, Leymus chinensis. J. Plant Growth Regul. 2008, 27, 39–48. [Google Scholar] [CrossRef]
- Al-Khaliel, A.S. Effect of salinity stress on mycorrhizal association and growth response of peanut infected by Glomus mosseae. Plant Soil Environ. 2010, 56, 318–324. [Google Scholar] [CrossRef]
- Tilak, K.V.B.R.; Ranganayaki, N.; Manoharachari, C. Synergistic effects of plant-growth promoting rhizobacteria and Rhizobium on nodulation and nitrogen fixation by pigeonpea (Cajanus cajan). Eur. J. Soil Sci. 2006, 57, 67–71. [Google Scholar] [CrossRef]
- Douglas, A.E. Conflict, cheats and the persistence of symbioses. New Phytol. 2008, 177, 849–858. [Google Scholar] [CrossRef] [PubMed]
- Bonfante, P.; Genre, A. Mechanisms underlying beneficial plant–fungus interactions in mycorrhizal symbiosis. Nat. Commun. 2010, 1, 48. [Google Scholar] [CrossRef] [PubMed]
- Kiers, E.T.; Duhamel, M.; Beesetty, Y.; Mensah, J.A.; Franken, O.; Verbruggen, E.; Fellbaum, C.R.; Kowalchuk, G.A.; Hart, M.M.; Bago, A. Reciprocal rewards stabilize cooperation in the mycorrhizal symbiosis. Science 2011, 333, 880–882. [Google Scholar] [CrossRef] [PubMed]
- Johnson, N.C.; Graham, J.H.; Smith, F.A. Functioning of mycorrhizal associations along the mutualism-parasitism continuum. New Phytol. 1997, 135, 575–585. [Google Scholar] [CrossRef]
- Kaldorf, M.; Koch, B.; Rexer, K.H.; Kost, G.; Varma, A. Patterns of interaction between Populus Esch5 and Piriformospora indica: A transition from mutualism to antagonism. Plant Biol. 2005, 7, 210–218. [Google Scholar] [CrossRef]
- Bois, G.; Bertrand, A.; Piche, Y.; Fung, M.; Khasa, D.P. Growth, compatible solute and salt accumulation of five mycorrhizal fungal species grown over a range of NaCl concentrations. Mycorrhiza 2006, 16, 99–109. [Google Scholar] [CrossRef]
- Flowers, T.J.; Munns, R.; Colmer, T.D. Sodium chloride toxicity and the cellular basis of salt tolerance in halophytes. Ann. Bot. 2015, 115, 419–431. [Google Scholar] [CrossRef]
- Li, Z.P.; Zhang, W.H.; Cui, Y.C. Effects of NaCl and Na2CO3 stresses on seed germination and seedling growth of Quercus variabilis. Acta. Ecol. Sin. 2015, 35, 742–751. [Google Scholar]
- Zhang, Z.; Wang, M.J.; Zhang, X.J.; Wang, W.B.; He, X.F.; Wang, R.; Wang, C.; Leng, P.S.; Mladenov, P.; Wang, W.H.; et al. Genome-wide identification and expression analysis of the ZIP gene family in Quercus dentata. Curr. Plant Biol. 2023, 35–36, 100291. [Google Scholar] [CrossRef]
- Zhao, Z.P.; Xie, B.; Wang, X.N.; Wang, Q.; Guo, C.; Zhang, F.; Wang, H.R.; Zhang, R.J.; Zhang, C. Adaptive growth strategies of Quercus dentata to drought and nitrogen enrichment: A physiological and biochemical perspective. Front. Plant Sci. 2024, 15, 1479563. [Google Scholar] [CrossRef] [PubMed]
- Liese, R.; Lübbe, T.; Albers, N.W.; Meier, I.C. The mycorrhizal type governs root exudation and nitrogen uptake of temperate tree species. Tree Physiol. 2018, 38, 83–95. [Google Scholar] [CrossRef] [PubMed]
- Hong, S.B.; Piao, S.L.; Chen, A.P.; Liu, Y.W.; Liu, L.L.; Peng, S.S.; Sardans, J.; Sun, Y.; Peñuelas, J.; Zeng, H. Afforestation neutralizes soil pH. Nat. Commun. 2018, 9, 520. [Google Scholar] [CrossRef] [PubMed]
- Yuan, C.X.; Wu, F.Z.; Peng, Y.; Wu, Q.Q.; Zhu, G.Q.; Zhao, Z.M.; Wang, Y.Q.; An, N.N.; Ni, X.Y.; Yue, K. Pain or gain: The dual role of afforestation effects on soil pH at the global scale. Plant Soil 2023, 493, 617–628. [Google Scholar] [CrossRef]
- Huang, Y.; Mónica, C.P.; Michael, D.M.; Janusz, J.Z. Responses of ectomycorrhizal Populus tremuloides and Betula papyrifera seedlings to salinity. Environ. Exp. Bot. 2008, 62, 357–363. [Google Scholar]
- Qin, Y.; Pan, X.Y.; Kubicek, C.; Druzhinina, I.; Chenthamara, K.; Labbé, J.; Yuan, Z.L. Diverse plant-associated pleosporalean fungi from saline areas: Ecological tolerance and nitrogen-status dependent effects on plant growth. Front. Microbiol. 2017, 8, 158. [Google Scholar] [CrossRef]
- Kernaghan, G.; Hambling, B.; Fung, M.; Khasa, D.J.R.E. In vitro selection of boreal ectomycorrhizal fungi for use in reclamation of saline-alkaline habitats. Restor. Ecol. 2002, 10, 43–51. [Google Scholar] [CrossRef]
Disclaimer/Publisher’s Note: The statements, opinions and data contained in all publications are solely those of the individual author(s) and contributor(s) and not of MDPI and/or the editor(s). MDPI and/or the editor(s) disclaim responsibility for any injury to people or property resulting from any ideas, methods, instructions or products referred to in the content. |
© 2025 by the authors. Licensee MDPI, Basel, Switzerland. This article is an open access article distributed under the terms and conditions of the Creative Commons Attribution (CC BY) license (https://creativecommons.org/licenses/by/4.0/).